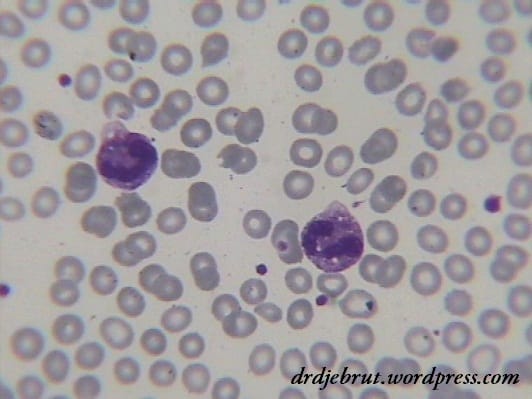
Neutrofil dengan Granulasi Toksik Menandakan Infeksi
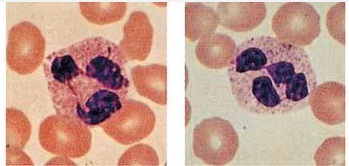
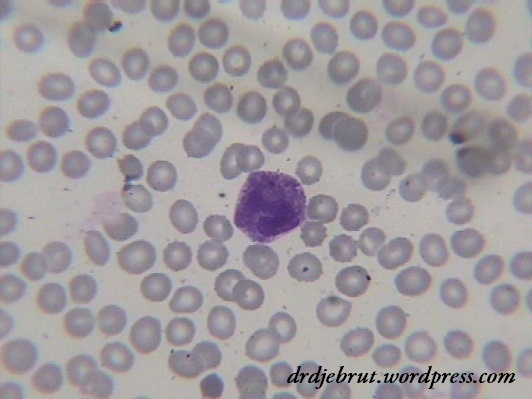
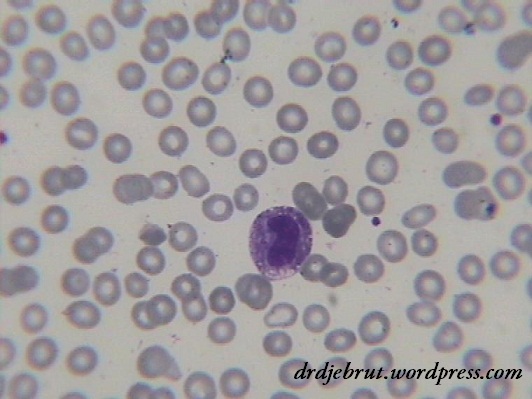

Neutrofil dengan Granulasi Toksik Menandakan Infeksi
Selain perubahan dari segi kuantitas atau jumlah, perubahan morfologi dari leukosit juga perlu diperhatikan. Salah satu perubahan morfologi yang cukup sering ditemui adalah granulasi toksik dari neutrofil.
Granulasi toksik (Greer et al., 2009)
Kita lihat dari gambar di atas, granulasi toksik merupakan granula sitoplasma dari neutrofil yang berwarna biru gelap atau ungu pada tahap metamielosit, stab, atau segmen. Seringkali granulasi toksik ini ditemukan pada pasien dengan infeksi yang berat. Coba kita bandingkan dengan neutrofil pada orang sehat di bawah ini.
Neutrofil normal (Greer at al., 2009)
Contohnya pada neutrofil yang saya temui pada salah satu pasien yang mengalami peningkatan jumlah leukosit dengan jumlah neutrofil sekitar 85%. Setelah dibuat hapusan darah tepi, banyak sekali ditemukan neutrofil dengan granula toksik. Kemudian di crosscheck dengan kondisi pasien, ternyata pasien memang sedang dalam keadaan sepsis.
Granulasi toksik pada pasien sepsis
Pada pasien ini, selain ditemukan granulasi toksik, juga ditemukan vakuolisasi sitoplasma. Adanya vakuolisasi sitoplasma ini dikatakan spesifik terhadap terjadinya infeksi, dan jika ditemukan bersama dengan toksik granulasi lebih mengarah kepada terjadinya infeksi sistemik.
Granulasi toksik dengan vakuolisasi sitoplasma
Semoga bermanfaat.
Sumber: Henry’s Clinical Diagnosis and Management by Laboratory Methods 21st ed.

![[Download] Pedoman Nasional Pelayanan Kedokteran Tata Laksana Thalassemia (KMK)](/content/images/uploads/2022/10/KMK.jpg)
![[Download] Pemeriksaan Laboratorium pada Thalassemia](/content/images/uploads/2022/09/cover-web-scaled.jpg)